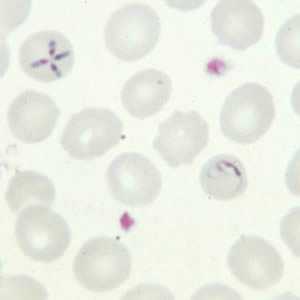
Figure C
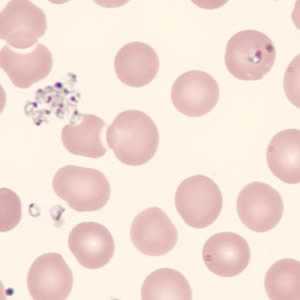
Figure C
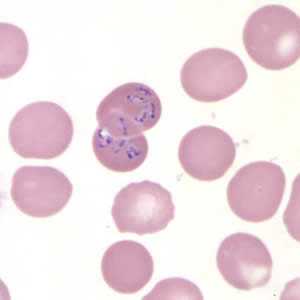
Figure C

Babesiosis
[Babesia divergens] [Babesia duncani] [Babesia microti] [Babesia MO-1]
Causal Agents
Babesiosis is caused by apicomplexan parasites of the genus, Babesia. While more than 100 species have been reported, only a few have been identified as causing human infections, including B. microti, B. divergens, B. duncani, and a currently un-named strain designated MO-1.
Life Cycle

The Babesia microti life cycle involves two hosts, which includes a rodent, primarily the white-footed mouse, Peromyscus leucopus, and a tick in the genus, Ixodes. During a blood meal, a Babesia-infected tick introduces sporozoites into the mouse host  . Sporozoites enter erythrocytes and undergo asexual reproduction (budding)
. Sporozoites enter erythrocytes and undergo asexual reproduction (budding)  . In the blood, some parasites differentiate into male and female gametes although these cannot be distinguished at the light microscope level
. In the blood, some parasites differentiate into male and female gametes although these cannot be distinguished at the light microscope level  . The definitive host is the tick. Once ingested by an appropriate tick
. The definitive host is the tick. Once ingested by an appropriate tick  , gametes unite and undergo a sporogonic cycle resulting in sporozoites
, gametes unite and undergo a sporogonic cycle resulting in sporozoites  . Transovarial transmission (also known as vertical, or hereditary, transmission) has been documented for "large" Babesia spp. but not for the "small" babesiae, such as B. microti
. Transovarial transmission (also known as vertical, or hereditary, transmission) has been documented for "large" Babesia spp. but not for the "small" babesiae, such as B. microti  .
.
Humans enter the cycle when bitten by infected ticks. During a blood meal, a Babesia-infected tick introduces sporozoites into the human host  . Sporozoites enter erythrocytes
. Sporozoites enter erythrocytes  and undergo asexual replication (budding)
and undergo asexual replication (budding)  . Multiplication of the blood stage parasites is responsible for the clinical manifestations of the disease. Humans are, for all practical purposes, dead-end hosts and there is probably little, if any, subsequent transmission that occurs from ticks feeding on infected persons. However, human to human transmission is well recognized to occur through blood transfusions
. Multiplication of the blood stage parasites is responsible for the clinical manifestations of the disease. Humans are, for all practical purposes, dead-end hosts and there is probably little, if any, subsequent transmission that occurs from ticks feeding on infected persons. However, human to human transmission is well recognized to occur through blood transfusions  .
.
Geographic Distribution
Worldwide, but little is known about the prevalence of Babesia in malaria-endemic countries, where misidentification as Plasmodium probably occurs. In Europe, most reported cases are due to B. divergens and occur in splenectomized patients. In the United States, B. microti is the agent most frequently identified (Northeast and Midwest), and can occur in nonsplenectomized individuals. Babesia duncani has been isolated in patients in Washington and California. MO-1 has been isolated from patients in Missouri.
Clinical Presentation
Most infections are probably asymptomatic, as indicated by serologic surveys. Manifestations of disease include fever, chills, sweating, myalgias, fatigue, hepatosplenomegaly, and hemolytic anemia. Symptoms typically occur after an incubation period of 1 to 4 weeks, and can last several weeks. The disease is more severe in patients who are immunosuppressed, splenectomized, and/or elderly. Infections caused by B. divergens tend to be more severe (frequently fatal if not appropriately treated) than those due to B. microti, where clinical recovery usually occurs.
Babesia sp. in thick blood smears stained with Giemsa.
Babesia parasites resemble Plasmodium falciparum, however Babesia has several distinguishing features: the parasites are pleomorphic (vary in shape and size), can be vacuolated, and do not produce pigment.

Figure A: Babesia sp. in thick blood smears stained with Giemsa.

Figure B: Babesia sp. in thick blood smears stained with Giemsa.
Babesia sp. in thin blood smears stained with Giemsa.

Figure A: Babesia sp. in a thin blood smear stained with Giemsa.

Figure B: Babesia sp. in a thin blood smear stained with Giemsa.

Figure C: Babesia sp. in a thin blood smear stained with Giemsa.

Figure D: Babesia sp. in a thin blood smear stained with Giemsa.

Figure E: Babesia sp. in a thin blood smear stained with Giemsa. Image contributed by the Arizona State Health Laboratory.

Figure F: Babesia sp. in a thin blood smear stained with Giemsa. Image contributed by the Arizona State Health Laboratory.
Babesia sp. (tetrad forms) in thin blood smears stained with Giemsa.

Figure A: Babesia sp. in a thin blood smear stained with Giemsa. Note the tetrads, a dividing form characteristic for Babesia.

Figure B: Babesia sp. in a thin blood smear stained with Giemsa. Note the tetrads, a dividing form characteristic for Babesia.
Figure C: Babesia sp. in a thin blood smear; note the tetrad form and ameboid trophozoite.

Figure D: Babesia sp. in a thin blood smear; tetrad form, pairs aligned.
Babesia sp. (extracellular forms) in a thin blood smear stained with Giemsa.

Figure A: Babesia sp. in a thin blood smear stained with Giemsa. Note the clumped extracellular forms indicative of Babesia.

Figure B: Babesia sp. in a thin blood smear stained with Giemsa. Note the extracellular forms as well as intra-erythrocytic forms, one of which is vacuolated.
Figure C: Babesia sp. in a thin blood smear stained with Giemsa, showing extracellular forms. Image was courtesy of the Connecticut Department of Public Health Laboratory.
Babesia microti in thin blood smears stained with Giemsa.

Figure A: Babesia microti in a thin blood smear stained with Giemsa. Babesia sp. cannot be identified to the species level by morphology alone; additional testing, such as PCR, is always recommended.

Figure B: Babesia microti in a thin blood smear stained with Giemsa. Babesia sp. cannot be identified to the species level by morphology alone; additional testing, such as PCR, is always recommended. Note the tetrad form in this image.

Figure C: Babesia microti in a thin blood smear stained with Giemsa. Note the intra-erythrocytic vacuolated forms indicated by the black arrows.
Babesia MO-1 in thin blood smears stained with Giemsa.

Figure A: Babesia MO-1 in a thin blood smear stained with Giemsa. Babesia sp. cannot be identified to the species level by morphology alone; additional testing, such as PCR, is always recommended. Note the vacuolated parasites (black arrows) in the image.

Figure B: Babesia MO-1 in a thin blood smear stained with Giemsa. Babesia sp. cannot be identified to the species level by morphology alone; additional testing, such as PCR, is always recommended. Note the vacuolated parasites (black arrows) in the image.
Figure C: Babesia MO-1 in a thin blood smear stained with Giemsa.

Figure D: Babesia MO-1 in a thin blood smear stained with Giemsa.

Figure E: Babesia MO-1 in a thin blood smear stained with Giemsa.

Figure F: Babesia MO-1 in a thin blood smear stained with Giemsa.

Figure G: Babesia MO-1 in a thin blood smear stained with Giemsa. Babesia sp. cannot be identified to the species level by morphology alone; additional testing, such as PCR, is always recommended.

Figure H: Babesia MO-1 in a thin blood smear stained with Giemsa. Babesia sp. cannot be identified to the species level by morphology alone; additional testing, such as PCR, is always recommended.

Figure I: Babesia MO-1 in a thin blood smear stained with Giemsa.

Figure J: Babesia MO-1 in a thin blood smear stained with Giemsa. Note the tetrad (black arrow).
Babesia duncani in a thin blood smear stained with Giemsa.
Babesia parasites resemble Plasmodium falciparum, however Babesia has several distinguishing features: the parasites vary more in shape and in size (pleomorphic), and they do not produce pigment.

Figure A: Babesia duncani in a thin blood smear stained with Giemsa. Babesia sp. cannot be identified to the species level by morphology alone; additional testing, such as PCR, is always recommended.
Ixodes spp., vectors of babesiosis.

Figure A: Larva (A), nymph (B), adult male (C), adult female (D), and engorged female with eggs (E) of Ixodes scapularis. Image courtesy of James Occi.

Figure B: Close-up of the head of a nymph of Ixodes. Notice the palps (PA) and hypostome (HY) are long, in comparison to the basis capituli (BC). Image courtesy of the Washington State Public Health Laboratories.

Figure C: Ventral view of the specimen in Figure B. Notice the inverted, U-shaped anal groove (AG). Also shown is one of the spiracular plates (SP).
Laboratory Diagnosis
Diagnosis can be made by microscopic examination of thick and thin blood smears stained with Giemsa. Repeated smears may be needed.
Antibody Detection
Diagnosis of Babesia infection should be made by detection of parasites in patients' blood smears. However, antibody detection tests are useful for detecting infected individuals with very low levels of parasitemia (such as asymptomatic blood donors in transfusion-associated cases), for diagnosis after infection is cleared by therapy, and for discrimination between Plasmodium falciparum and Babesia infection in patients whose blood smear examinations are inconclusive and whose travel histories cannot exclude either parasite.
The indirect fluorescent antibody test (IFA) using B. microti parasites as antigen detects antibodies in 88-96% of patients with B. microti infection. IFA antigen slides are prepared using washed, parasitized erythrocytes produced in hamsters. Patients' titers generally rise to ≥1:1024 during the first weeks of illness and decline gradually over 6 months to titers of 1:16 to 1:256 but may remain detectable at low levels for a year or more. Specificity is 100% in patients with other tick-borne diseases or persons not exposed to the parasite. Cross-reactions may occur in serum specimens from patients with malaria infections, but generally titers are highest with the homologous antigen.
The extent of cross-reactivity between Babesia species is variable. A negative result with B. microti antigen for a patient exposed on the West Coast may be a false-negative reaction for Babesia infection. Individuals whose exposure could have occurred on the West Coast should be tested also for antibodies to the Babesia duncani, because of the lack of cross-reactivity with B. microti.
Reference:
Krause PJ, Telford S RI, Ryan R, et al. Diagnosis of babesiosis: Evaluation of a serologic test for the detection of Babesia microti antibody. J Infect Dis 1994;169:923-926.

Molecular diagnosis
In some infections with intraerythrocytic parasites, the morphologic characteristics observed on microscopic examination of blood smears do not allow an unambiguous differentiation between Babesia and Plasmodium. Moreover, potential blood donors may have subclinical symptoms and very low parasitemia, undetectable in blood smears. In such cases, the diagnosis can be derived from molecular techniques, such as PCR. In addition, molecular approaches are very valuable in investigations of new Babesia variants (or species) observed in recent human infections in the United States and in Europe.
References:
1. Hojgaard A, Lukacik G, Piesman J. Detection of Borrelia burgdorferi, Anaplasma phagocytophilum and Babesia microti, with two different multiplex PCR assays. Ticks and Tick-borne Diseases 2014 (5):349–351.
2. Bonnet S, Jouglin M, Malandrin L, Becker C, A. Agoulon A, L’Hostis M, Chauvin A. Transstadial and transovarial persistence of Babesia divergens DNA in Ixodes ricinus ticks fed on infected blood in a new skin-feeding technique. Parasitol 2007;134:197–207.
Treatment Information
Most asymptomatic persons do not require treatment. Health care providers may consult CDC staff about whether to treat someone who has babesiosis, what type(s) of therapy to use, how to monitor the status of the infection, and how long to treat. Treatment decisions should be individualized, especially for patients who have (or are at risk for) severe or relapsing infection.
For ill patients, babesiosis usually is treated for at least 7-10 days with a combination of two prescription medications — typically either:
- atovaquone PLUS azithromycin; OR
- clindamycin PLUS quinine (this combination is the standard of care for severely ill patients).
The typical daily doses for adults are provided in the table below.
| Drug | Adult dosage (usually treat for at least 7-10 days) |
|---|---|
| Atovaquone | 750 mg orally twice a day |
| along with | |
| Azithromycin | On the first day, give a total dose in the range of 500-1000 mg orally; on subsequent days, give a total daily dose in the range of 250-1000 mg |
| or | |
| Clindamycin | 600 mg orally 3 times a day or 300-600 mg intravenously 4 times a day |
| along with | |
| Quinine | 650 mg orally 3 times a day |
Some patients—including those with severe illness—might require or benefit from supportive care, such as:
- antipyretics;
- vasopressors (if the blood pressure is low and unstable);
- blood transfusions;
- exchange transfusions (in which portions of a patient’s blood or blood cells are replaced with transfused blood components);
- mechanical ventilation; or
- dialysis
Atovaquone
Atovaquone is available for human use in the United States.
Note on Treatment in Pregnancy
Atovaquone is in pregnancy category C. Data on the use of atovaquone in pregnant women are limited, and the risk to the embryo-fetus is unknown. Because data are available about safe administration of quinine plus clindamycin during pregnancy, this drug combination, rather than atovaquone (plus azithromycin), generally is recommended for treatment of symptomatic babesiosis during pregnancy, unless the preferred medications are not available or tolerated.
Pregnancy Category C: Either studies in animals have revealed adverse effects on the fetus (teratogenic or embryocidal, or other) and there are no controlled studies in women or studies in women and animals are not available. Drugs should be given only if the potential benefit justifies the potential risk to the fetus.
Note on Treatment During Lactation
Note on Treatment in Pediatric Patients
Azithromycin
Azithromycin is available for human use in the United States.
Note on Treatment in Pregnancy
Note on Treatment During Lactation
Note on Treatment in Pediatric Patients
Clindamycin
Clindamycin is available for human use in the United States.
Note on Treatment in Pregnancy
Note on Treatment During Lactation
Note on Treatment in Pediatric Patients
DPDx is an education resource designed for health professionals and laboratory scientists. For an overview including prevention and control visit www.cdc.gov/parasites/.
- Page last reviewed: October 17, 2016
- Page last updated: October 17, 2016
- Content source:
- Global Health – Division of Parasitic Diseases and Malaria
- Notice: Linking to a non-federal site does not constitute an endorsement by HHS, CDC or any of its employees of the sponsors or the information and products presented on the site.
- Maintained By:


 ShareCompartir
ShareCompartir